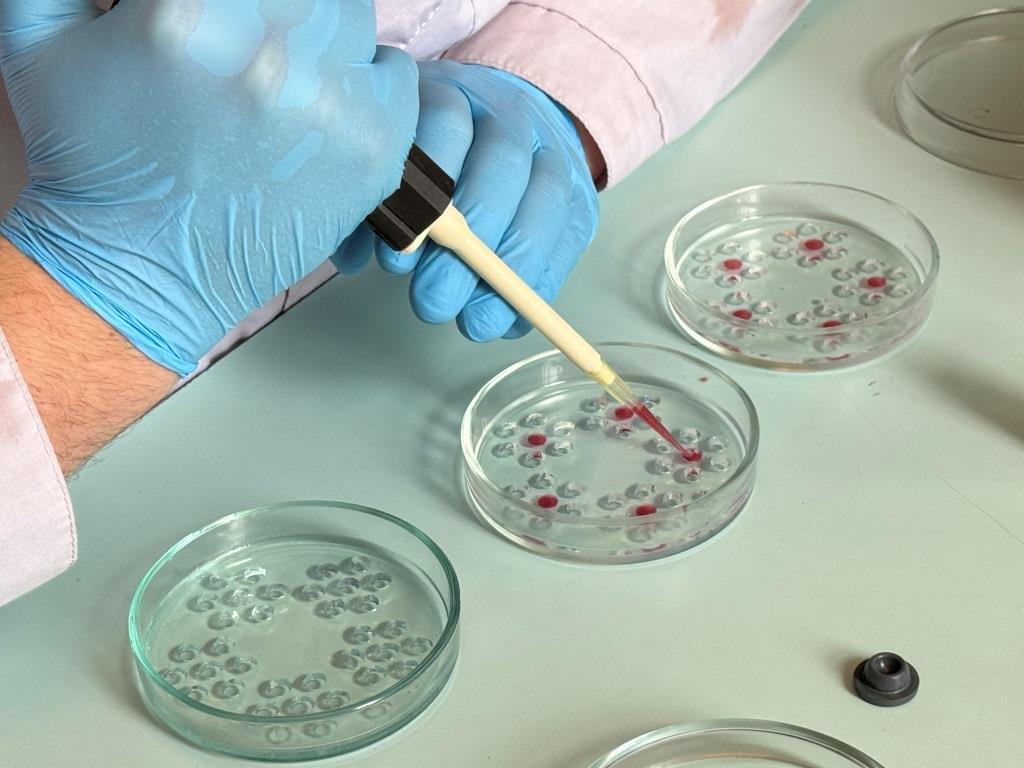

E-mail: priemnaya@kubzv.ru
Тел.: 8 (861) 260-87-72
младший научный сотрудник
Тыщенко
Ксения Алексеевна

E-mail: priemnaya@kubzv.ru
Тел.: 8 (861) 260-87-72
младший научный сотрудник
Романенко
Диана Владиславовна

E-mail: priemnaya@kubzv.ru
Тел.: 8 (861) 260-87-72

младший научный сотрудник
Шаталова
Алина Владимировна
кандидат ветеринарных наук, ведущий научный сотрудник с вмененными обязанностями по руководству отделом терапии и акушерства
Староселов
Михаил Александрович
E-mail: priemnaya@kubzv.ru
Тел.: 8 (861) 260-87-72
кандидат ветеринарных наук, заслуженный ветеринарный врач Кубани, ведущий научный сотрудник
Схатум
Аминет Кадыровна

E-mail: priemnaya@kubzv.ru
Тел.: 8 (861) 260-87-72

E-mail: priemnaya@kubzv.ru
Тел.: 8 (861) 260-87-72
младший научный сотрудник
Черкашин
Вячеслав Владимирович

E-mail: priemnaya@kubzv.ru
Тел.: 8 (861) 260-87-72
младший научный сотрудник
Копылов
Данила Вячеславович

E-mail: priemnaya@kubzv.ru
Тел.: 8 (861) 260-87-72

лаборант-исследователь
Бондаренко
Анна Дмитриевна
младший научный сотрудник
Яковец
Маргарита Геннадиевна
E-mail: priemnaya@kubzv.ru
Тел.: 8 (861) 260-87-72
лаборант-исследователь
Концедайло
Виктория Феликсовна

E-mail: priemnaya@kubzv.ru
Тел.: 8 (861) 260-87-72

• Услуги отдела
• Сотрудники отдела
• Разработки отдела
• Общая информация

Проведение гематологического исследования крови
Отоскопия кошки

Выполнение гостематики в телятнике на базе ООО КХ «Участие»
Постановка РИД для выявления лейкоза КРС
Общая информация
Разработки отдела
Перспективные разработки отдела, продукция и услуги:
Исследования причины возникновения вторичных иммунодефицитных.
Разработка методологий диагностики, средств и схем профилактики и терапии ИД состояний.
Разработка методов диагностики, эффективных средств и схем профилактики и терапии акушерско-гинекологических болезней коров незаразной, бактериальной, микозной и вирусной этиологии.
Разработка методов воздействия на субпопуляции крупного рогатого скота с целью получения животных с улучшенными хозяйственно-ценными признаками с использование генетических методов.
Разработки мероприятий по оздоровлению хозяйств/ферм от лейкоза крупного рогатого скота.
Ученые ФГБНУ «Краснодарский научный центр по зоотехнии и ветеринарии» могут предложить:
1. Исследование болезней органов дыхания и пищеварения вирусной, бактериальной и смешанной этиологии у сельскохозяйственных животных
2. Исследования причин возникновения вторичных иммунодефицитных состояний у продуктивных животных, разработка методологии
диагностики, средств и схем профилактики и терапии ИД состояний, респираторных и желудочно-кишечных болезней, контроль колострального и поствакцинального иммунитета
3. Бактериологические, микологические исследования биоматериала, патологического материала, экссудатов, транссудатов, кормов, воды, контроль качества дезинфекции.
4. Серологические исследования на вирусные инфекции животных в РТНГА, РНГА, РТГА, ИФА, с расшифровкой результатов и научным сопровождением, гематологические исследования с использованием автоматизированного анализатора «Mythic 18 vet» (Швецария), иммунологические исследования
5. Полное эпизоотологическое обследование хозяйств, ферм, разработка научно обоснованных мероприятий по борьбе с респираторными и желудочно-кишечными болезнями с/х животных.
6. Эпизоотологическое обследование хозяйств, разработка научно обоснованных мероприятий по оздоровлению хозяйств/ферм от лейкоза крупного рогатого скота. Гематологические исследования с использованием автоматизированного анализатора «Mythic 18 vet» (Швецария) при выявлении больных лейкозом КРС животных. Серологические исследования на лейкоз КРС в РИД и ИФА
7. Исследования акушерско-гинекологических болезней коров незаразной, бактериальной, микозной и вирусной этиологии, схемы профилактики и терапии.
Коллектив отдела состоит из высококвалифицированных ученых: одного доктора наук, трех кандидатов наук, научных сотрудников и лаборантов.
На разработки отдела получены 2 патента и одна заявка на патент на изобретения и полезные модели, 2 монографии, 3 методических рекомендаций.
За последние 5 лет (2016 - 2020гг.) сотрудниками отдела было опубликовано 80 научных статей, в том числе 26 – в изданиях, рекомендуемых ВАК, 6 – базах WoS и Scopus, 2 монографии, 3 методических рекомендаций, 2 патента и 1 заявка на патент РФ, 4 учебных и учебно-методических изданий.
Подготовлена 1 докторская диссертация. В отделе 3 докторанта и 2 аспиранта.
Наиболее значимые разработки:
Проводится исследование болезней органов дыхания и пищеварения вирусной, бактериальной и смешанной этиологии у сельскохозяйственных животных. Исследуются причины возникновения вторичных иммунодефицитных состояний у продуктивных животных, разрабатываются методология диагностики, средства и схемы профилактики и терапии ИД состояний, респираторных и желудочно-кишечных болезней, контроль колострального и поствакцинального иммунитета. Проводятся бактериологические, микологические исследования биоматериала, патологического материала, экссудатов, транссудатов, кормов, воды, контроль качества дезинфекции. Серологические исследования на вирусные инфекции животных в РТНГА, РНГА, РТГА, ИФА, с расшифровкой результатов и научным сопровождением, гематологические исследования с использованием автоматизированного анализатора «Mythic 18 vet» (Швецария), иммунологические исследования. Полное эпизоотологическое обследование хозяйств, ферм, разработка научно обоснованных мероприятий по борьбе с респираторными и желудочно-кишечными болезнями с/х животных.
Проводятся исследования акушерско-гинекологических болезней коров незаразной, бактериальной, микозной и вирусной этиологии, разрабатываются методы диагностики, эффективные средства и схемы профилактики и терапии. Проводится акушерско-гинекологическая диспансеризация коров, бактериологические, микологические молока, маточных истечений, серологические исследования, сыворотки крови, качественные показатели молока. Ведется научная тематика по разработке методов воздействия на субпопуляции крупного рогатого скота с целью получения животных с улучшенными хозяйственно-ценными признаками с использование генетических методов.
Эпизоотологическое обследование хозяйств, разработка научно обоснованных мероприятий по оздоровлению хозяйств/ферм от лейкоза крупного рогатого скота. Гематологические исследования с использованием автоматизированного анализатора «Mythic 18 vet» (Швецария) при выявлении больных лейкозом КРС животных. Серологические исследования на лейкоз КРС в РИД и ИФА.
Отдел терапии и акушерства

Проведение микроскопического исследования для идентификации микроорганизмов

Ректальная термометрия собаки
Учет реакции РИД лейкоза КРС
Определение сроков стельности коровы

Количественное определение уровня цитокинов в секрете из носовой полости телят









